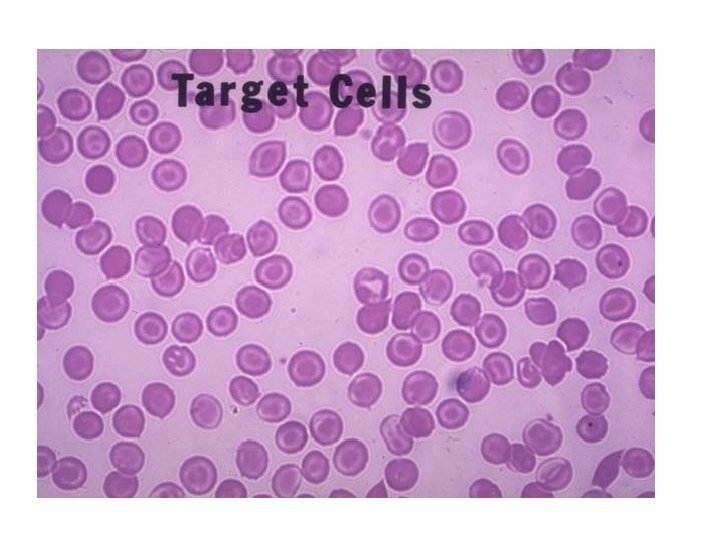

PERFERK YAYMA PY HAZIRLANMASI BOYANMASI Deerlendirilmesi PY Klinik

PERİFERİK YAYMA (PY) HAZIRLANMASI BOYANMASI Değerlendirilmesi

PY Klinik Kullanım Alanları • • • Anemi, hemoliz ? Orak Hücreli anemi ? Trombositopeni ? Nötropeni? Lenfoma/Lenfo. Proliferatif Hastalık(LPH)? Miyelo. Proliferatif Hastalık ? Tüketim Koagülopatisi “DIC” ? Retinal incelemede kanama +/-optik atrofi ? Yaymada tanınabilecek paraziter/ mikrobiyal hst ? Hematopoetik kökenli olmayan kanser hücreleri ? Genel durumun bozukluğu, ateş, düşkünlük, kilo kaybı…… Otomatik TKS da sonuç alınamayan bir parametre olması

Yöntem • Periferik yaymalar (PY) lam ya da lamel üzerine hazırlanabilir. • Lamel kullanmanın tek avantajı, lökositlerin daha homojen dağılabilmesidir. • Genellikle tercih edilen yöntem, yaymanın lam üzerine yapılmasıdır (lam daha zor kırılır, üstüne isim yazılabilir, boyama sırasında daha kolay tutulabilir. . . ).

Periferik Kandan Yayma Yapılması

İyi bir yayma için • Temiz, tozdan arındırılmış lamlar kullanılmalıdır. • Lamın kenarından (uzun eksen) 2 -3 mm içeriye orta hatta ufak bir damla kan koyulur • Hızla, lamın üzerine damlanın az ilerisine düzgün kenarlı (traşlı) bir başka lam 30 -45 açı ile yerleştirilerek hafifçe geri itilir; damlaya değmesi ve damlanın lam kenarı boyunca yayılması sağlanır. Bu yayılma olur olmaz lam seri olarak öne doğru 45 açıyla itilerek kan damlasının peşinden sürüklenerek lama yayılması sağlanır. Lamlar kurutularak tespit edilir. • Tespit etmeden 24 saat veya daha uzun bekletilen lamlarda boyama yapıldığında zeminde kuruyan plazma boyandığında soluk mavi bir renk görülmesine sebep olur

Periferik Yayma Hazırlanması Kötü İyi

Lamların işaretlenmesi Lam üzerine hasta adı ve numarası, tarih yazılmalıdır. Bu amaçla grafit kalemler kullanılabilir. Rodajlı lamlar kullanılıyorsa, buzlu cam kısmı, kurşun kalem ile yazı yazmaya elverişlidir. Kullanılan kalem, alkole dayanıklı bir boya içermelidir. Aksi takdirde boyama işlemleri sırasındaki alkol teması, tüm yazıların silinmesine sebep olacaktır. Etiket ile işaretleme, gerekirse, boyama işlemi tamamlandıktan sonra yapılmalıdır.

Tespit(Fiksasyon) • Saf metanol kullanılır. • Yaymalar havada kurutulduktan sonra boyama işlemine başlamadan önce tesbit edilmesi önerilir • Ancak boyama işlemi hemen yapılmayacaksa yaymalar mutlaka saf metanol ile tespit edilmelidir. Aksi takdirde plazmaya bağlı mavi, bulanık bir zemin boyanması sorun yaratabilir.

Boyalar Romanowsky boyaları kullanılır. Bu boyalar çeşitli tiazin ve eozin bileşenlerinden oluşmaktadır. – Wright – Giemsa – May Grüwald – Giemsa, – Leishman boyaları kullanılabilecek bazı boya örnekleridir.

Teknik • Boyama işlemi genellikle horizontal duran lamların üzerine boya dökülerek uygulanır • Alternatif yöntemde preparatlar tespit-boya solusyonları içine daldırarak boyanabilir. • Bu daldırma işleminin yapılabildiği kaplar şale olarak da adlandırılıp; iç yüzlerinde lamların yerleştirilebileceği kanallar mevcuttur. • Boyayı lam üstüne yayma yönteminde, boyadaki çözücünün buharlaşması, boyanın dibe çökmesi gibi bazı hata kaynakları ortadan kalkmaktadır.


Boyama işlemi: Alternatif I a. Lamlar havada kurutulur b. Lamlar 1 -2 dk saf , mutlak metanol ile tespit edilir. Metanol kalitesi çok önemli olup; kesinlikle aseton içermemelidir. c. Lam silkelenerek metanol uzaklaştırılır. d. Lamların üzerine üstünü örtecek kadar saf boya çözeltisi dökülüp; 2 dk bekletilir e. Üzerine boyaya eşit miktarda tampon dökülerek boya ile karışması sağlanır 3 -5 dk daha bekletilir; ancak lam kenarlarından taşma olmamalıdır. f. Lam üzerindeki boya, lam horizontal durumdayken, su aracılığı ile lamın üzerinden akıtılır. g. Otuz saniye çeşme suyu ile yıkanıp, lamın arka yüzü gazlı bezle temizlenir ve slayt hafifçe eğimli olarak kurumaya bırakılır. h. İstenirse bir lamel ile kapatılır. Lamelin lam üzerine tutunabilmesi için kanada balsamı ya da diğer bir “mounting medium” kullanılır.

Şale

Boyama işlemi : Alternatif II a. Lamlar yazılı kısımları üstte olacak şekilde şaleye yerleştirilir. b. Üzerine metanol dökülerek 2 dk tespit edilir c. Lamlar, Wright boyası bulunan şaleye daldırılarak 4 dk bekletilir d. Lamlar, Wright- tamponu bulunan şaleye daldırılıp; arada karıştırarak 2025 dk bekletilir. e. Lamları içinde 5 ml metanol ve 200 ml deiyonize su bulunan şaleye daldırarak boyanın akması sağlanır f. Yıkama işlemini deiyonize su ile 3 kez daha tekrarlanır (şaleye 7 -8 kere daldırıp çıkarak). Her yeni lam serisinde deiyonize su değiştirilmelidir. g. Lamların arkasında kalan boya artıkları gazlı bir bez ile nazikçe temizlenerek lamlar havada kurutulup değerlendirmeye geçilir.

“Mounting medium” kullanılması Beklemeye bağlı boyanın solmasını engeller

Periferik Yaymanın Boyanması • Tespit (saf metanol ile ) • Boyama (Romanowsky tipi boyalar ile) – Wright- Giemsa – May- Grünwald – Giemsa • Yıkama

Püf noktaları • Kapiller kan örneği tercih edilir, venöz kan kullanılacaksa antikoagülan olarak EDTA kullanılmalıdır. • Yayma işlemi tanımlandığı gibi, dikkatle yapılmalıdır • Yaymaların en az 5 dk oda ısında kuruması beklenmelidir. • Tercihan 2 saat içinde boyanmalıdır, gecikme olacaksa yaymalar, metanolde tesbit edilip; yatay konumda kurutulmalıdır (yıllarca bile dayanabilir). • İyi boyanmamış preparatlar tekrar boyanabilir. Bu amaçla 50 m. L deiyonize suya 1 damla glasiyel asetik asit damlatılıp, lamlar bu solusyona daldırılıp çıkarılarak boyası akıtılır. Eski preparatlarda bu işlem için gereken süre daha uzundur. • Boyama süresince su ile temastan kaçınılmalıdır. Boyaların nemli ortamda beklemesi, özellikle metanolün hidrasyonuna ve zamansız iyonlaşmasına sebep olacaktır • Ortamda ( ör: komşu bir laboratuvar) aseton buharının bulunması bile boyama işlemini olumsuz etkiler. Aseton ile kontaminasyondan kaçınmak için boya ile temas eden tüm kaplar metanol ile yıkanmalıdır.

Sorunlar: Artefaktların görülmesi Genellikle: • Örneğin kötü yayılmasından • Yaymanın nemli ortamda, yavaş kurutulmasından (hücreler büzüşebilir). • Fiksasyonun yapılmaması ya da gecikmiş olarak yapılmasından, tespit solusyonuna su bulaşmasından kaynaklanır. Su bulaşması büyük morfolojik artefaktlara (kalıntılara) sebep olur, hücrelerin canlı görünümü kaybolur, edinsel vakuoller gözlenir (hücre içinde boşluk görünümü) • Preparat üzerinde kalıntıların görülmesi boyama sürecinde lam üstünde kurumalar olmasından (yetersiz boya koyulursa) ya da yıkamanın yetersiz olmasından kaynaklanabilir. Yıkamaya başlarken lamın horizontal tutulmaması da çevreden düşen bir tozun gelip çökmesine sebep olabilir

Sorunlar: Koyu mavi boyanma • • • Yayma kalındır Boyada uzun süre tutulmuştur Yetersiz yıkanmıştır Kullanılan tampon istenenden daha alkalidir. Bu durumlarda eritrositler mavi ya da yeşilimsi renk verir, Nuklear kromatin koyu mavi-siyah bir görüntü verir. Nötrofillerin granülleri beklenenden fazla boyanıp; büyük ve koyu görünürler. Eozinofillerin granülleri mavi-gri seçilir. • Süreyi kısaltıp, yıkamayı arttırmak, yayma kalınlığını inceltmek gibi yollar ile sorun giderilebilir.

Sorunlar: Fazla Pembe Boyanma: • • • Boyada kısa süre tutulması Aşırı yıkama işlemi Kurumadan preparatın üstünün lamel ile kapatılması Boyanın istenenden daha asit olması, asidofiliye sebep olur Eritrositler parlak ve kırmızı ya da portakal rengindedir Nuklear kromatin, soluk mavidir. Eozinofillerin granülleri parlak kırmızı renk verir Ortamdaki havanın asit buharı içermesi de rengin asidofilik olmasına sebep olabilir. Problemin nedeni, boyanın PH sının düşük olması ya da metanol dür. Metanol bekleme ile formik asit oluşturarak bozulma gösterebilir.

Diğer Problemler. • Renklerin genelde soluk olması boyada geçen sürenin kısa olması ya da fazla yıkama yapılması ile açıklanabilir. • Dejeneratif değişiklikler • (ör: monosit/nötrofillerde sitoplazmik vakuol oluşumu, çekirdekte lobülasyon, çekirdekli hücrelerde parçalanma, apoptotik değişiklikler) genellikle yaymanın hazırlanmasından değil, tespit edilmeden/boyanmadan uzun süre bekletilmesinden kaynaklanır.

Periferik Yaymanın Değerlendirilmesi • Makroskopik • Mikroskopik – 100(10 x 10) kez büyütme – 1000(100 x 10) kez büyütme

Kalın Uygun İstenen yayma kalitesi Soğuk Aglutininler + Kriyoglobulin

İncelenecek alan 14 1 3 7 5 2 6 Örnek uygulama noktası





Mikroskopik inceleme • Lokositler – Formül Lokosit – Morfolojik anomali varlığı? – Atipik hücreler ? • Eritrositler – Çap? – Hemoglobin içeriği ? – Yapısal özellikler ? – Çekirdekli eritrosit ? • Trombositler – Sayı (TKS ile karşılaştırma)? – Büyüklük? – Küme, satellit oluşumu?

Periferik yayma kalitesini etkileyen faktörler • • Örnek tipi (kapiller kan tercih edilmeli) Örnek kalitesi (ısı etkisi, dilüsyon, ) Yaymanın kalitesi Yeterince kuruması, tespit Kullanılan sarf malzeme kalitesi (lam, metanol, boya, tamponlar, p. H ) Boyama tekniği

Değerlendirme • TKS verileri ve • Klinik bilgilerle birleştirilerek yapılmalıdır • Gerekirse ileri tetkiklere başvurulur

ISININ ETKİSİ

Tesbit Etmeden Bekletmenin Etkisi- Eritrositler

Tesbit Etmeden Bekletmenin Etkisi- Lokositler

Su ile kontaminasyon Etkisi

kriyoglobulin

Eski kan veya hipertonik bir solüsyonla karşılaşmanın etkisi



Mikrositler




Hipokromi

polikromatofili

Rulo Formasyonu Plazma Hücresi

Bazofilik noktalanma

Howell jolly


Trombosit sayısı normal


Trombosit sayısı düşük

Trombosit Agregataları

LÖKOSİT FORMÜLÜ Lenfosit Monosit Nötrofil Segment Bant Atipik Eozinofil Bazofil 5 2 4 6 18 65 100

Büyük trombosit kümeleri Satellit oluşumu megakaryosit Dev trombosit Normal trombosit Candida glabrata


Miyeloblast Promiyelosit Metamiyelosit Bant Segment


Nötrofillerde enfeksiyona bağlı değişiklikler Vakuolizasyon Toksik granulasyon Sola kayma




MONOSİT

LENFOSİT Atipik LENFOSİT

- Slides: 66